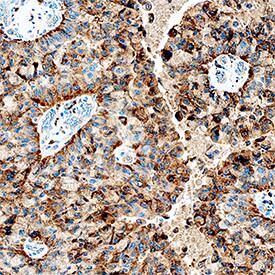
Cathepsin C/DPPI antibody in Human Lung Cancer Tissue by Immunohistochemistry (IHC-P).

Human Cathepsin C/DPPI Antibody
R&D Systems, part of Bio-Techne | Catalog # AF1071


Key Product Details
Validated by
Species Reactivity
Validated:
Cited:
Applications
Validated:
Cited:
Label
Antibody Source
Product Specifications
Immunogen
Asp25-Leu463
Accession # P53634
Specificity
Clonality
Host
Isotype
Scientific Data Images for Human Cathepsin C/DPPI Antibody
Detection of Human Cathepsin C/DPPI by Western Blot.
Western blot shows lysates of A549 human lung carcinoma cell line. PVDF membrane was probed with 1 µg/mL of Goat Anti-Human Cathepsin C/DPPI Antigen Affinity-purified Polyclonal Antibody (Catalog # AF1071) followed by HRP-conjugated Anti-Goat IgG Secondary Antibody (Catalog # HAF019). A specific band was detected for Cathepsin C/DPPI at approximately 55 kDa (as indicated). This experiment was conducted under reducing conditions and using Immunoblot Buffer Group 1.Detection of Human Cathepsin C/DPPI by Simple WesternTM.
Simple Western lane view shows lysates of A549 human lung carcinoma cell line, loaded at 0.2 mg/mL. A specific band was detected for Cathepsin C/DPPI at approximately 56 kDa (as indicated) using 50 µg/mL of Goat Anti-Human Cathepsin C/DPPI Antigen Affinity-purified Polyclonal Antibody (Catalog # AF1071) followed by 1:50 dilution of HRP-conjugated Anti-Goat IgG Secondary Antibody (Catalog # HAF109). This experiment was conducted under reducing conditions and using the 12-230 kDa separation system. Non-specific interaction with the 230 kDa Simple Western standard may be seen with this antibody.Cathepsin C/DPPI in Human Lung Cancer Tissue.
Cathepsin C/DPPI was detected in immersion fixed paraffin-embedded sections of human lung cancer tissue using Goat Anti-Human Cathepsin C/DPPI Antigen Affinity-purified Polyclonal Antibody (Catalog # AF1071) at 1 µg/mL overnight at 4 °C. Tissue was stained using the Anti-Goat HRP-DAB Cell & Tissue Staining Kit (brown; Catalog # CTS008) and counterstained with hematoxylin (blue). Specific staining was localized to cytoplasm in cancer cells. View our protocol for Chromogenic IHC Staining of Paraffin-embedded Tissue Sections.Applications for Human Cathepsin C/DPPI Antibody
Immunohistochemistry
Sample: Immersion fixed paraffin-embedded sections of human lung subjected to Antigen Retrieval Reagent-Basic (Catalog # CTS013) and immersion fixed paraffin-embedded sections of human lung cancer tissue
Simple Western
Sample: A549 human lung carcinoma cell line
Western Blot
Sample: A549 human lung carcinoma cell line
Formulation, Preparation, and Storage
Purification
Reconstitution
Formulation
Shipping
Stability & Storage
- 12 months from date of receipt, -20 to -70 °C as supplied.
- 1 month, 2 to 8 °C under sterile conditions after reconstitution.
- 6 months, -20 to -70 °C under sterile conditions after reconstitution.
Background: Cathepsin C/DPPI
Cathepsin C, also known as dipeptidyl-peptidase I (DPPI), is a cysteine protease of the papain family (1). Cathepsin C sequentially removes dipeptides from the free N-termini of proteins and peptides. It has broad specificity except that it does not cleave a basic amino acid (Arg or Lys) in the N-terminal position or Pro on either side of the scissle bond. It requires halide ions for activity. The pro form contains a pro peptide and a catalytic region, which can be further processed into heavy/ alpha and light/ beta chains that are linked by a disulfide bond. It is broadly distributed. Cathepsin C plays a role in the lysosomal degradation. It also functions as a key enzyme in the activation of granule serine proteases in cytotoxic T lymphocytes and natural killer cells (granzymes A and B), mast cells (tryptase and chymase), and neutrophils (Cathepsin G and elastase) by removing their N-terminal activation dipeptides (2). Loss of function mutations in the Cathepsin C gene result in periodontal disease and palmoplantar keratosis (3).
References
- Turk, B. et al. (2004) in Handbook of Proteolytic Enzymes (ed. Barrett, A.J. et al.) p. 1192, Academic Press, San Diego.
- Dahl, S.W. et al. (2001) Biochemistry 40:1671.
- Toomes, A.J. et al. (1999) Nat. Genet. 23:421.
Alternate Names
Gene Symbol
UniProt
Additional Cathepsin C/DPPI Products
Product Documents for Human Cathepsin C/DPPI Antibody
Product Specific Notices for Human Cathepsin C/DPPI Antibody
For research use only